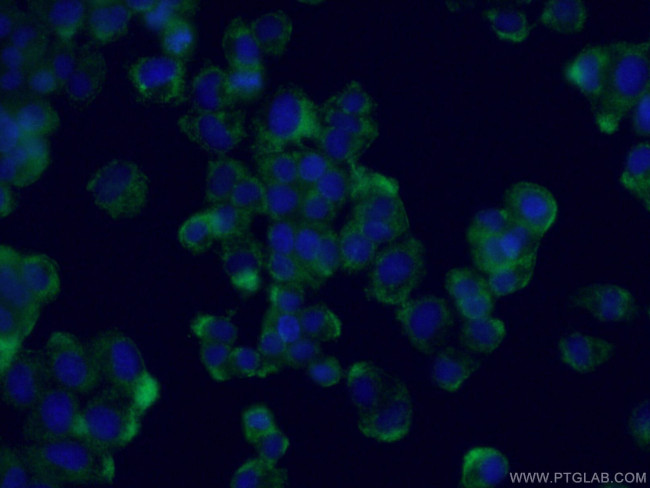
NUMBL Antibody in Immunocytochemistry (ICC/IF)

Search
Proteintech
NUMBL Monoclonal Antibody (5F6E1)
{{$productOrderCtrl.translations['antibody.pdp.commerceCard.promotion.promotions']}}
{{$productOrderCtrl.translations['antibody.pdp.commerceCard.promotion.viewpromo']}}
{{$productOrderCtrl.translations['antibody.pdp.commerceCard.promotion.promocode']}}: {{promo.promoCode}} {{promo.promoTitle}} {{promo.promoDescription}}. {{$productOrderCtrl.translations['antibody.pdp.commerceCard.promotion.learnmore']}}
产品信息
66155-1-IG
种属反应
宿主/亚型
分类
类型
克隆号
抗原
偶联物
形式
浓度
纯化类型
保存液
内含物
保存条件
运输条件
产品详细信息
Immunogen sequence: MNKLRQSLR RRKPAYVPEA SRPHQWQADE DAVRKGTCSF PVRYLGHVEV EESRGMHVCE DAVKKLKAMG RKSVKSVLWV SADGLRVVDD KTKDLLVDQT IEKVSFCAPD RNLDKAFSYI CRDGTTRRWI CHCFLALKDS GERLSHAVGC AFAACLERKQ RREKECGVTA AFDASRTSFA REGSFRLSGG GRPAEREAPD KKKAEAAAAP TVAPGPAQPG HVSPTPATTS PGEKGEAGTP VAAGTTAAAI PRRHAPLEQL VRQGSFRGFP ALSQKNSPFK R (1-280 aa encoded by BC001794)
靶标信息
Plays a role in the process of neurogenesis. Required throughout embryonic neurogenesis to maintain neural progenitor cells, also called radial glial cells (RGCs), by allowing their daughter cells to choose progenitor over neuronal cell fate. Not required for the proliferation of neural progenitor cells before the onset of embryonic neurogenesis. Also required postnatally in the subventricular zone (SVZ) neurogenesis by regulating SVZ neuroblasts survival and ependymal wall integrity. Negative regulator of NF-kappa-B signaling pathway. The inhibition of NF-kappa-B activation is mediated at least in part, by preventing MAP3K7IP2 to interact with polyubiquitin chains of TRAF6 and RIPK1 and by stimulating the 'Lys-48'-linked polyubiquitination and degradation of TRAF6 in cortical neurons. [UniProt]
仅用于科研。不用于诊断过程。未经明确授权不得转售。
篇参考文献 (0)
生物信息学
蛋白别名: numb homolog (Drosophila)-like; numb homolog-like; Numb-like protein; Numb-R; Numb-related protein
基因别名: CAG3A; CTG3a; NBL; NUMB-R; NUMBL; NUMBLIKE; NUMBR; TNRC23
UniProt ID: (Human) Q9Y6R0, (Mouse) O08919
Entrez Gene ID: (Human) 9253, (Mouse) 18223